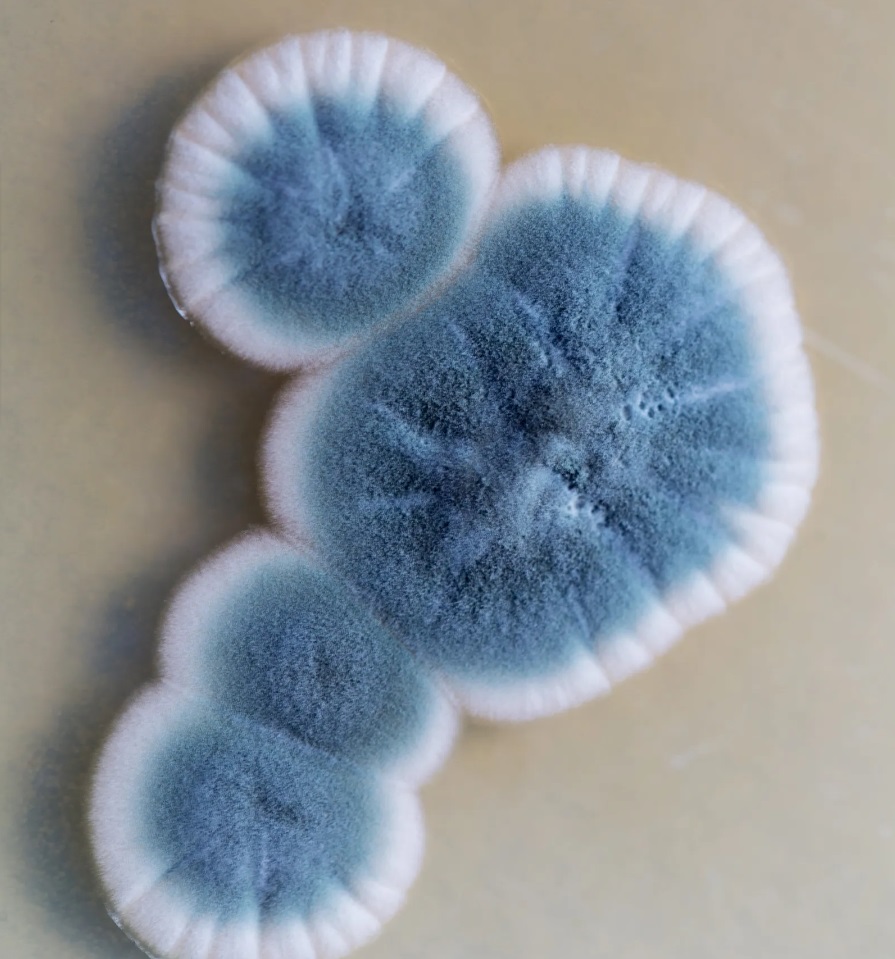

plíseň
|
|
Plíseň (plísně) je typ mikroskopických organismů, který se vyskytuje ve formě viditelných kolonií na povrchu organických materiálů, jako jsou potraviny, dřevo, papír, textilie, stěny, koupelny a další vlhká místa. Plísně jsou eukaryotické organismy, což znamená, že mají jadérko a organely obklopené membránami. Existuje mnoho různých druhů plísní, ale většina z nich patří do skupiny houby zvané hyfy. Hyfy jsou tenké, nitkovité vlákna, která tvoří většinu plísňových kolonií. Tyto vlákna jsou schopna rychle rostoucích a tvoří výtrusy, které umožňují plísním šířit se do nových prostředí. Plísně se vyskytují všude kolem nás a jsou běžnou součástí přírody. Některé druhy jsou užitečné, například v potravinářském průmyslu pro výrobu sýrů a léčivých produktů. Nicméně, v interiérech budov nebo v domácnostech mohou plísně představovat problém, zejména pokud se přemnoží a vytvářejí nadměrné množství vlhkosti nebo jsou přítomny ve velkém množství. Vlhkost, teplota a dostupnost živin jsou klíčové faktory, které ovlivňují růst plísní. Plísně se často vyskytují na místech s vysokou vlhkostí, jako jsou koupelny, kuchyně, podlahy a stěny blízko vodovodních potrubí nebo ve vlhkých podkrovích. Přítomnost plísní ve vnitřních prostředích může mít negativní dopad na lidské zdraví, zejména u lidí s alergiemi nebo respiračními problémy. Plísně mohou uvolňovat alergeny a toxiny do vzduchu, což může způsobit různé zdravotní potíže. Prevence plísní zahrnuje udržování nízké vlhkosti v prostorách, dobrou ventilaci, opravu netěsností a odstraňování plísní a vlhkých materiálů. Pokud je plíseň rozšířená a obtížná k odstranění, může být nezbytné použít profesionální ošetření. Pamatujte, že k odstranění plísní a řešení problémů s plísněmi by mělo vždy docházet s ohledem na zdraví a bezpečnost. Existuje mnoho druhů plísní, které se liší svým vzhledem, biologickými charakteristikami a preferencemi prostředí. Některé z nejběžnějších druhů plísní zahrnují: Penicillium: Penicillium je rod plísní, který zahrnuje několik druhů. Některé druhy Penicillium jsou užitečné v potravinářství (např. Penicillium roqueforti pro výrobu sýrů) nebo při výrobě antibiotik (Penicillium chrysogenum). Aspergillus: Aspergillus je rod plísní s mnoha druhy. Některé druhy Aspergillus mohou způsobit alergické reakce nebo infekce u lidí, zejména u jedinců s oslabeným imunitním systémem. Alternaria: Alternaria je rod plísní, který je běžně nalézána v půdě, rostlinách a vzduchu. Některé druhy Alternaria mohou způsobovat alergie u citlivých jedinců. Cladosporium: Cladosporium je další rod plísní, který se vyskytuje na rostlinách a ve venkovním vzduchu. Tato plíseň může být alergenem pro některé lidi. Stachybotrys chartarum: Tato plíseň je známá jako "černá plíseň" a je často spojována s vlhkými a zchátralými prostředími. Stachybotrys chartarum produkuje mykotoxiny, které mohou mít negativní dopad na zdraví. Fusarium: Fusarium je rod plísní, který může infikovat rostliny a způsobovat hnilobu plodin. Některé druhy Fusarium mohou také vyvolávat infekce u lidí. Rhizopus: Rhizopus je rod plísní, který zahrnuje druhy, které jsou často spojovány s rozkladem organických materiálů. |